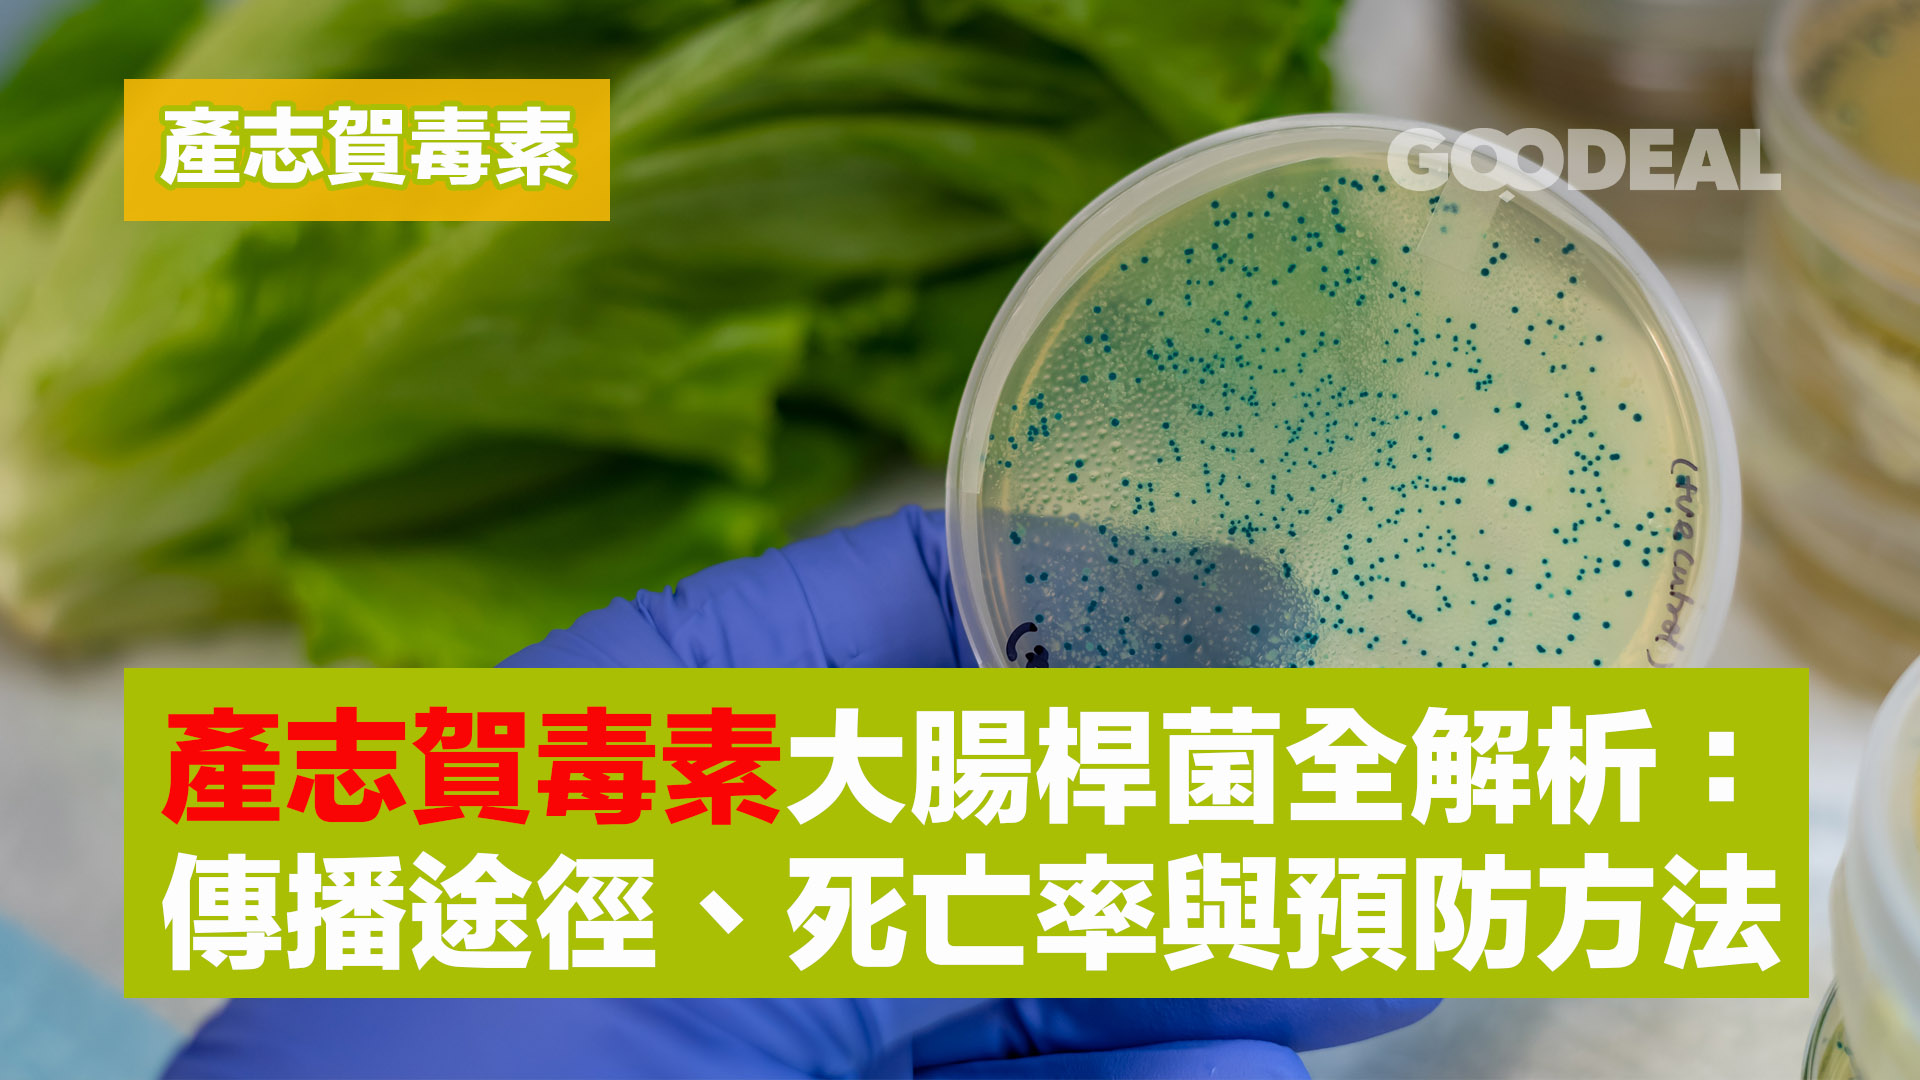
article-cover

最近瑪嘉烈醫院員工出現產志賀毒素感染群組,更有一名約30歲腫瘤科男醫生死亡,令市民關注起這個陌生的名字:產志賀毒素大腸桿菌,究竟是甚麼?
產志賀毒素大腸桿菌(Shiga toxin-producing Escherichia coli,簡稱 STEC 或 VTEC)是一種可能引發嚴重疾病的病原體,近年來因多宗食源性感染事件而受到全球關注。本文將深入解析其特性、傳播途徑、致死風險,並提供實用預防指南,幫助市民遠離感染威脅。
一、什麼是產志賀毒素大腸桿菌(STEC)?
1. 基本定義
STEC 是大腸桿菌(E. coli)的一種亞型,其特徵是能產生 志賀毒素(Shiga toxin)。這種毒素會破壞人體細胞,尤其是血管內皮細胞與紅血球,導致溶血性尿毒綜合症(HUS)等致命併發症。
2. 常見血清型
最知名的血清型為 O157:H7 ,但其他如 O26、O45、O103、O111 等也可能致病,不同地區的主要流行型別可能有所差異。
3. 感染風險族群
- 兒童(5 歲以下):HUS 發生率最高
- 老年人:免疫力較弱,併發症風險高
- 免疫缺陷者:如癌症患者、HIV感染者
二、傳播途徑:產志賀毒素如何感染人體?
產志賀毒素主要透過「糞口途徑」傳播,以下為常見媒介:
1. 受污染的食物
- 未煮熟的肉類:特別是碎牛肉(漢堡肉),因加工過程可能混入腸道細菌
- 生乳與乳製品:未經巴氏殺菌的牛奶、芝士
- 生鮮蔬果:使用受污染水源灌溉或清洗(如萵苣、芽菜)
- 交叉污染:生熟食共用刀具、砧板
2. 受污染的水源
- 飲用或接觸遭動物糞便污染的井水、河水
- 游泳池或水上樂園因腹瀉患者排泄而污染
3. 人際接觸
- 照顧感染者時未徹底洗手
- 觸摸農場動物(如牛、羊)後未清潔
4. 其他媒介
- 未妥善處理的醃製或發酵食品
- 昆蟲(如蒼蠅)接觸污染物後傳播
三、產志賀毒素感染症狀與死亡率
1. 典型病程
- 潛伏期:1-10 天(平均 3-4 天)
- 初期症狀:
- 嚴重腹痛、水狀腹瀉
- 噁心、嘔吐、輕微發燒
- 重症指標:
- 腹瀉轉為血便(出血性大腸炎)
- 少尿、皮膚蒼白(貧血徵兆)
- 神經系統症狀(抽搐、昏迷)
2. 致死風險:溶血性尿毒綜合症(HUS)
- 發生率:約 5-15% 的 STEC 感染者會發展為 HUS
- 主要危害:
- 腎衰竭(需透析治療)
- 血小板減少、微血管血栓
- 死亡率約 5-10%,兒童與長者風險更高
- 長期後遺症:
- 慢性腎病、高血壓
- 神經功能損傷(如癲癇、失明)
3. 全球疫情數據
- 根據 WHO 統計,每年全球約有 100 萬例 STEC 感染,其中 10% 需住院治療。
- 已開發國家因飲食習慣(生食文化)及畜牧業規模,病例數較高。
四、關鍵預防措施:遠離產志賀毒素感染
1. 食品安全管理
- 徹底加熱食物:肉類中心溫度需達 70°C 以上,碎牛肉避免半生食用。
- 生熟分離:使用不同砧板、刀具,避免交叉污染。
- 慎選乳製品:僅購買經巴氏殺菌的牛奶及衍生產物。
- 清洗蔬果:流動清水沖洗 30 秒以上,葉菜類逐片處理。
2. 個人衛生習慣
- 正確洗手時機:
- 處理食物前、如廁後
- 接觸動物或農場環境後
- 手部清潔重點:使用肥皂搓揉至少 20 秒,指縫、指甲縫需徹底清潔。
3. 飲用水安全
- 戶外活動時避免飲用未煮沸的山泉水、溪水。
- 安裝過濾設備。
4. 高風險族群防護
- 兒童、老人避免食用生芽菜、未滅菌乳酪。
- 接觸農場動物後更換衣物,並立即洗澡。
五、感染後處置與治療
1. 就醫時機
若出現 血便、無尿超過 12 小時、持續嘔吐 等症狀,應立即前往急症室。
2. 治療原則
- 禁止使用止瀉藥:可能延長毒素停留腸道時間。
- 謹慎使用抗生素:某些抗生素會誘導細菌釋放更多志賀毒素。
- 支持性療法:
- 靜脈輸液補充電解質
- 輸血或血小板(嚴重貧血時)
- 腎透析(HUS 患者)
3. 隔離與通報
感染者應暫停烹飪、照顧幼兒,直至症狀消失 48 小時後。醫療機構需依法通報有關單位,以追蹤感染來源。
六、常見問題(FAQ)
Q1:冷凍能否殺死 STEC?
冷凍僅抑制細菌繁殖,無法滅菌,解凍後仍具感染風險。
Q2:有機食品是否更安全?
有機農法可能使用動物糞肥,若未充分堆肥反而風險較高,需嚴格清洗。
▲ 即 Like Goodeal 早早鳥 專頁
▲ Follow Instagram @goodeal.hk 觀看精選內容